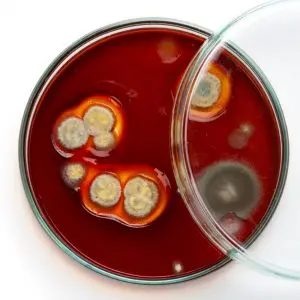

Recent Posts
- Make Every Room Work: A Homeowner’s Guide to Interior Design That Actually Helps
- Landscaping on a Budget: Ways to Create a Beautiful Your Yard Without Overspending
- Buy a House with Confidence: A Complete Guide for Smart Homebuyers
- Transform Your Space: Bathroom Upgrades You Can DIY
- Termite Infestations: The Silent Threat That Could Be Eating Your Home
Archives
- June 2026
- May 2026
- April 2026
- March 2026
- February 2026
- January 2026
- December 2025
- November 2025
- October 2025
- September 2025
- August 2025
- July 2025
- June 2025
- May 2025
- April 2025
- March 2025
- February 2025
- January 2025
- December 2024
- November 2024
- October 2024
- September 2024
- August 2024
- July 2024
- June 2024
- May 2024
- April 2024
- March 2024
- February 2024
- January 2024
- December 2023
- November 2023
- October 2023
- September 2023
- August 2023
- July 2023
- June 2023
- May 2023
- April 2023
- March 2023
- February 2023
- January 2023
- December 2022
- November 2022
- October 2022
- September 2022
- August 2022
- July 2022
- June 2022
- May 2022
- April 2022
- March 2022
- February 2022
- January 2022
- December 2021
- November 2021
- October 2021
- September 2021
- August 2021
- July 2021
- June 2021
- May 2021
- April 2021
- March 2021
- February 2021
- January 2021
- December 2020
- November 2020
- October 2020
- September 2020
- August 2020
- July 2020
- June 2020
- May 2020
- April 2020
- March 2020
- February 2020
- January 2020
- December 2019
- November 2019
- October 2019
- September 2019
- August 2019
- July 2019
- June 2019
- May 2019
- April 2019
- March 2019
- February 2019
- January 2019
- December 2018
- November 2018
- October 2018
- September 2018
- August 2018
- July 2018
- June 2018
- May 2018
- April 2018
- March 2018
- February 2018
- January 2018
- December 2017
- November 2017
- October 2017
- September 2017
- March 2017
- February 2017
- January 2017
- December 2016
- November 2016
- October 2016
- September 2016
- August 2016
- June 2016
Categories
- Attic
- Bearing on support
- Community
- DIY Tips and Tricks
- Drain System
- Floor Structure
- Foundation and Piers
- Fuel Supply and Distribution
- Furnace Systems
- Gutters and Downspouts
- Healthy and Safe Home
- Home Buyers
- Home Drainage
- Home Exterior
- Home Improvement
- Home Inspections
- Home Maintenance
- Home Safety
- Home Structural Components
- Home Systems and Components
- Home Ventilation
- Homeowners
- Lintels
- Mold and Fungi
- Plumbing
- Plumbing maintenance
- Real Estate
- Repair Verification
- Roof Covering
- Roof Structure
- Roof System
- Safe and Healthy Home
- Seasonal
- Uncategorized
- Ventilation System
- Water damage
- Window Maintenance
- Wood Destroying Insects